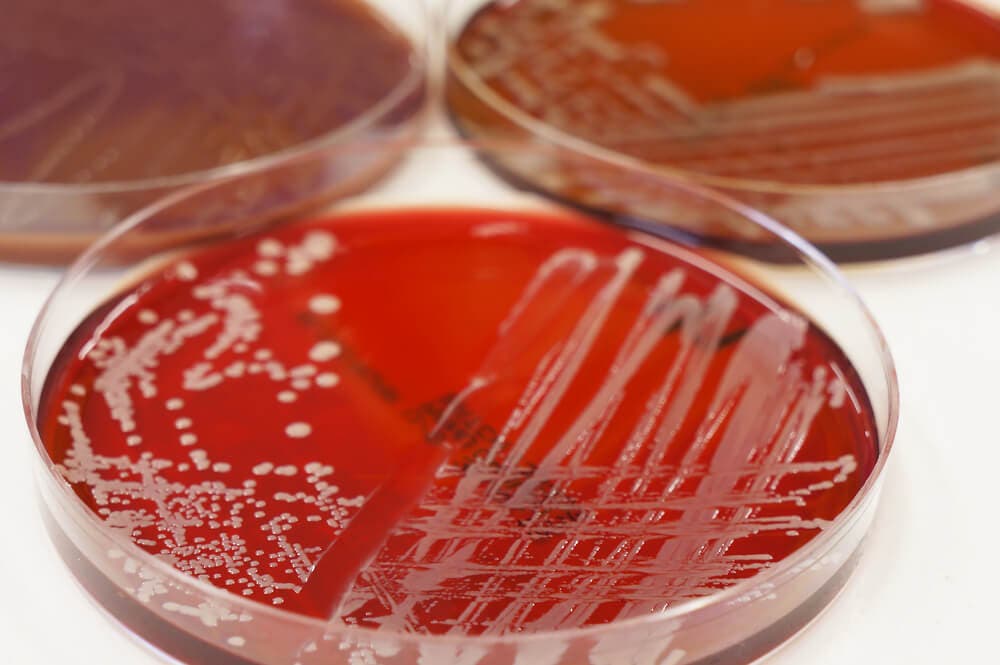

Bacitracina: qué es y cómo actúa


Revisado y aprobado por el biotecnólogo Alejandro Duarte
La bacitracina es un medicamento que se aplica en caso de sufrir lesiones leves en la piel. Ahora bien, para ser más precisos, se trata de un polipéptido producido por Bacillus subtilis, siendo la que más se utiliza la bacitracina A.
Se trata de un antibiótico cuyo mecanismo de acción es similar al de las penicilinas o cefalosporinas. Inhibe la síntesis de la pared celular de las bacterias. En concreto, la bacitracina es eficaz frente a bacterias gram+. Es muy utilizada por vía tópica para tratar infecciones oculares, dérmicas y orofaríngeas.
¿Qué es un bacteria gram+?
Muchas veces habréis leído que un antibiótico es activo frente a bacterias gram+, gram- o frente a ambas y no sabéis a que se refiere. Pues bien, los primeros fármacos, los que son activos solo frente a un tipo de bacteria se llaman antibacterianos de espectro reducido, mientras que los antibióticos que son activos frente a todas las bacterias son los de amplio espectro.
Las bacterias gram+ o gram- se diferencian en la estructura de sus membranas celulares. En el primer caso, la bacteria va a presentar una membrana formada por péptidoglucano y, una membrana citoplasmática interna formada por una doble capa de lípidos.
- Los lípidos son un conjunto de biomoléculas que están formadas principalmente por carbono e hidrógeno, y en menor medida por oxígeno.
A diferencia de las gram+, las bacterias gram- tienen, además de la membrana interna citoplasmática, otra bicapa lipídica en la membrana más externa y entre estas dos el espacio periplasmático. Este espacio está compuesto por péptidoglucano, que es mucho más grande y ancho que en el caso de las bacterias gram+.
Descubre: ¿Qué es y para qué sirve la penicilina?
¿Cómo se sabe se si trata de una bacteria gram+ o gram-?
En el laboratorio, cuando se hacen los cultivos celulares, una de las primeras técnicas que se llevan a cabo para indentificar la bacteria causante de la enfermedad, es la tinción de Gram.
Esta técnica consiste en aplicar al cultivo celular un colorante, violeta de genciana por ejemplo. A continuación se añade alcohol-acetona para desteñir las bacterias gram-. Después se añade otro colorante, la fucsina, que teñirá de rosa las bacterias que no se han teñido en el paso anterior, que serían las gram+.
El color que dé esta tinción depende de las características de la membrana. Así los microbiólogos pueden ir diferenciando los tipos de bacterias.
Mecanismo de acción de la bacitracina
La bacitracina es un antibiótico bactericida, es decir que, mediante su mecanismo de acción, es capaz de provocar la muerte al microorganismo.
Es importante distinguir entre un fármaco bacteriostático y otro bactericida. En el primer caso, lo que va a hacer el medicamento será impedir el crecimiento de la bacteria. El bactericida produce directamente la muerte de ella.
En el caso de la bacitracina, para llevar a cabo su acción bactericida lo que va a hacer es impedir la regeneración del lípido transportador del péptidoglicano (pared que rodea la membrana). Por lo tanto, al no poder sintetizar la membrana celular, la bacteria se morirá. Dicha pared es una estructura imprescindible para que la bacteria pueda vivir.
Farmacocinética
La bacitracina es un fármaco que no se administra por vía oral por ser un fármaco de naturaleza peptídica. Por ello, se debería administrar por vía intramuscular. Pero, como se trata de una inyección muy dolorosa, se limita a la vía tópica.

En el caso en el que se necesite la inyección intramuscular, las concentraciones máximas del antibiótico se obtienen a la 1-2 horas. Es un fármaco que se distribuye ampliamente por el cuerpo pero no es capaz de atravesar la barrera hematoencefálica a menos que las meninges se encuentren inflamadas.
Para su eliminación, la bacitracina recurre a la vía renal, excretándose lentamente por filtración glomerular. Entre el 10 % y el 40 % de la dosis que se administra por esta vía se excreta en orina de 24 horas. El resto del fármaco se desconoce si es destruido o sufre metabolismo.
Ver también: ¿Quieres mantener tu salud? No acabes con las bacterias
Reacciones adversas
El efecto adverso más importante de la bacitracina es su nefrotoxicidad, por ello no se puede administrar por vía parenteral. Aún así, aunque el antibiótico se aplique tópicamente o mediante una inyección intramuscular, esta reacción adversa se puede llegar a desencadenar.

Se debe monitorizar la función renal, acompañada de una ingesta adecuada de líquidos para prevenir problemas renales. Aparte de la nefrotoxicidad, también puede dar lugar a diferentes síntomas, aunque solo en raras ocasiones, como:
- Fiebre.
- Prurito.
- Urticaria.
- Eosinofilia.
- Toxicidad hematológica.
- Reacciones anafilácticas.
Además, como ocurre con muchos antibióticos, un tratamiento de larga duración con bacitracina puede hacer que se desarrollen infecciones, sobre todo fúngicas.
La administración de este medicamento debe hacerse bajo supervisión médica. La automedicación es perjudicial y trae graves consecuencias.
Todas las fuentes citadas fueron revisadas a profundidad por nuestro equipo, para asegurar su calidad, confiabilidad, vigencia y validez. La bibliografía de este artículo fue considerada confiable y de precisión académica o científica.
- Schalock, P. C., & Zug, K. A. (2005). Bacitracin. Cutis. https://doi.org/10.2165/00128415-200812230-00022
- Charlebois, A., Jalbert, L. A., Harel, J., Masson, L., & Archambault, M. (2012). Characterization of Genes Encoding for Acquired Bacitracin Resistance in Clostridium perfringens. PLoS ONE. https://doi.org/10.1371/journal.pone.0044449
- Rietk??tter, E., Hoyer, D., & Mascher, T. (2008). Bacitracin sensing in Bacillus subtilis. Molecular Microbiology. https://doi.org/10.1111/j.1365-2958.2008.06194.x
Este texto se ofrece únicamente con propósitos informativos y no reemplaza la consulta con un profesional. Ante dudas, consulta a tu especialista.







